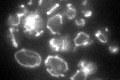
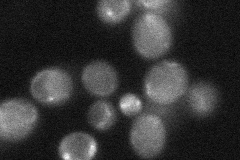

View description
Mitochondrial protein required for respiratory growth; mutant phenotype and genetic interactions suggest a role in delivering mt mRNAs to ribosomes; located on matrix face of the inner membrane and loosely associated with mitoribosomes
Localization:
Intensity:
Fold change:
Significance:
-
C’ GFP library in SD
mitochondria54.61 -
N' NOP1pr-GFP in SD

mitochondria53.512 -
N' TEF2pr-mCherry in SD

missing0 -
N' NATIVEpr-GFP in SD
cytosol,mitochondria31.0014 -
N' TEF2pr-VC and Cyto-VN in SD

#N/A0 -
C’ GFP library in SD+DTT

mitochondria58.181.06No -
C’ GFP library in SD+H2O2

mitochondria64.571.18No -
C’ GFP library in Starvation Media

mitochondria41.270.75No -
C’ GFP library on the background of Pup2-DaMP

mitochondria -
C’ GFP library on the background of CCT mutant

mitochondria63.72341.1666No
